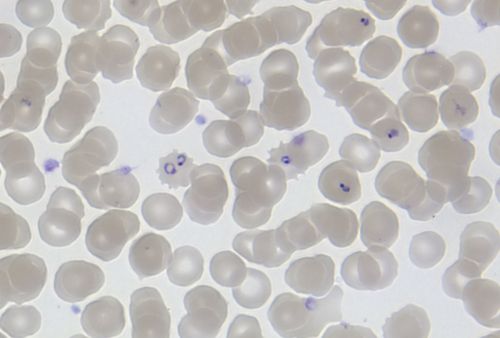

Movement
Respiration
Sense
Growth
Reproduction
Excretion
Nutrition
|
Next
Chapter 2: Systems in the human body
|
Chapter overview
2 weeks
This chapter introduces learners to the cell. They may have encountered the cell before, but here we will look at the structure of cells, including the organelles common to most eukaryotic cells. We will also look at the differences between plant and animal cells. Later we look at the hierarchical organisation of cells into tissues then into organs then into systems and then into an organism. Some information has been included on specialised cells. This was thought to be important to introduce the idea of a biological structure being adapted to its function to ensure functional efficiency. To be able to describe and explain how a structure is adapted to its perform its functions is an important skill in Life Sciences, especially if learners carry on with the subject in Gr. 10-12. This is an ideal opportunity to start practicing and also to realise that there is huge variety in the types, sizes, and shapes of cells depending on their function.
Learners also have to make a 3D model of a cell in this chapter. This activity may be treated as a project. A suggestion is to turn to this activity at the start so that learners are aware of this and can start thinking about their models at home and what they could use to make them as you are going through the content and learning about the cell. You could then set a deadline for the model, for example one week after you finish this chapter (ie. three weeks then from when you start the chapter), for them to have completed their models.
IMPORTANT NOTE
1.1 Cell structure (2.5 hours)
|
Tasks |
Skills |
Recommendation |
|
Activity: Brainstorm the Seven Functions of Life |
Recalling information, listing |
Optional |
|
Activity: Summarise what you have learnt |
Recalling information, identifying, writing |
Suggested |
1.2 Differences between plant and animal cells (2 hours)
|
Tasks |
Skills |
Recommendation |
|
Activity: Identify differences between plant and animal cells |
Comparing, identifying, describing, writing |
CAPS suggested |
|
Activity: Comparing plant and animal cells |
Comparing, describing |
CAPS suggested |
|
Activity: Cell 3D model |
Planning, constructing, identifying, describing |
CAPS suggested |
1.3 Cells in tissues, organs and systems (1.5 hours)
|
Tasks |
Skills |
Recommendation |
|
Activity: Evaluating microscopic images |
Examining, observing, comparing |
CAPs suggested |
|
Activity: Making a wet mount with onion and cheek cells |
Preparing and examining specimens, observing, recording, writing |
CAPS suggested |
|
Activity: Research the discovery of light and electron microscopes |
Researching, writing |
CAPS suggested |
In this chapter we will learn about the basic units of life which enable all of functions within living organisms - cells.
All the New words listed in the boxes in the margin are defined in the glossary at the end of this strand.
This website has many interesting articles about science and science-related jobs. They have been classified according to topics and also provide tips on how to incorporate the articles into your classroom and what questions to ask. If you are interested in incorporating real world science into your classroom, this is one website to start looking at: http://www.sciencenewsforkids.org/news-in-the-classroom
In this section you'll often read the prefix cyto- as in cytoplasm, cytosol or cytoskeleton. Cyto- means cell so if you read cytoskeleton it actually says: cell-skeleton.
All living organisms, including plants, animals, bacteria and fungi, are made up of cells. Cells are the smallest parts of all living organisms.
If we look at all the living organisms in the world we see that there are two main types of organisms based on the structures of their cells. The most important difference in structure is the presence of a nucleus. Cells that contain a nucleus are classified as eukaryotic cells, while those without a nucleus are prokaryotic cells. In this chapter we will specifically look at eukaryotic cells that make up organisms such as plants and animals. Examples of organisms with prokaryotic cells are bacteria.
In Gr. 7 CAPS, learners would have learnt about the classification system of organisms into the 5 kingdoms, namely; Bacteria, Protista, Fungi, Plants and Animals. This is a good opportunity to remind learners of this and ask them if they remember what the 5 kingdoms are.
We call the study of cells cytology, -cyto meaning 'cell' and -logy meaning 'study', while -logist refers to the person who does the studying.
Do you remember the test you learnt about in previous grades to decide whether an organism is living or non-living? Perhaps you had an mnemonic to remember the seven processes, such as "MRS GREN".
Movement
Respiration
Sense
Growth
Reproduction
Excretion
Nutrition
Cells are the smallest unit of life and are therefore living.
This is a chance for learners to express their opinion. As we have not yet learned about cells in any great detail, they might not yet agree with the fact that an individual cell is living. Allow learners to express their opinions and justify them. You can also come back to this question at the end of the chapter and reflect on the answers to see if the learners might have changed their minds.
We can say that cells are the basic structural and functional units of all living organisms. You cannot see individual cells with the naked eye, because they are too small - you need to use a microscope to be able to see cells. We say cells are microscopic because they can only be seen under a microscope.
We use the phrase "with the naked eye" to explain that we are looking at something using only our eyes, without the help of a telescope or microscope.

Robert Hooke was the first cytologist to identify cells under his microscope in 1665. He decided to call the microscopic shapes that he saw in a slice of cork "cells" because the shapes reminded him of the cells (rooms) that the monks in the nearby monastery lived in.

The Visit boxes in the margins contain links to interesting websites and videos. Simply type the link exactly as it is into the address bar in your browser.
Wrap your head around how tiny a cell is by visiting this website http://learn.genetics.utah.edu/content/begin/cells/scale/
Remember, the prefix "micro-" means very small. When we say something is microscopic it means it is so small that it can only be seen under a microscope.

As an entry point to this section, you may want to use these types of questions to ask at the start of the lesson: Do you think all cells are the same? If they are not the same, can you think of reasons why they differ or how they might differ? Discuss your thoughts with the class.
Your body is made up of many different kinds of cells. We say your cells are specialised to perform a specific function. Depending on the function of the cell, it can be specialised by having a different shape or size or may have some components which other cells do not have. Have a look at the differences between nerve cells and red blood cells in the images.
Ask your learners to describe the differences in shape between the nerve cells and the red blood cells in the images. Take note however, that the images have been coloured in afterwards - these are not the real colours of the cells, so learner must not say that nerve cells are green, etc.
As an extension ask them how they think the shape helps with the function of the cells. Describing how the structure of a particular biological component is suited to (adapted to) its function (ie. functional efficiency) is a very important skill in Life Sciences and should be developed from early on. You can give brief descriptions of the function of the cells:


Biconcave means hollow on both sides.
Even though there are many different types of cells, there are components of the cell structure which are common to all cells. There are also some structures which most, but not all, cells have. Let us take a look at this in the next section.
As an introduction to the cell organelles teachers might want to show learners one or two of the YouTube songs included in the margin. They offer a fun entry-point into this topic.
Videos about the cell and cell organelles. and
As we have mentioned before, all cells have some common structures. These are:
a cell membrane
cytoplasm; and
Let's now have a look at the structure of these components of the cell, and some of the other organelles common to cells. An organelle is a specialised structure within the cell that performs a function for the cell. Examples of organelles in cells are vacuoles and mitochondria. Look at the diagram which identifies the different components in a simple animal cell.

All cells have a cell membrane around them. The cell membrane is a thin layer that encloses the cell's contents and separates the cell from its environment.
Many different substances have to pass in and out of a cell in order for it to function. The cell membrane controls which substances are allowed to enter and leave the cell. We say the cell membrane is selectively permeable. The organelles are also surrounded by membranes.
If something is 'permeable', then it means that substances, such as gases and liquids, can pass through it freely.
In order to explain the idea of 'selective permeability', you could use the analogy of a gate and security wall around someone's home - explain that only certain people get access to a private home and the gate serves to deny access to undesirable people. Also waste products in the form of garbage bags are put outside the perimeter fencing to be removed and food and water is allowed to enter. As with viruses and diseases, thieves and criminals can however still penetrate the home's defences and will then attack the owners/cell organelles.
In Natural Sciences we speak of a medium when we talk about a solution in which organelles, cells or organs are grown or suspended. Can you think of other meanings for the word medium?
The cytoplasm is often referred to as the jelly-like substance within cells. This is only partly true as the cytoplasm actually consists of the jelly-like substance (called cytosol) and all the cell organelles (except the nucleus). The term for the combined cytoplasm (cytosol + organelles) and the nucleus (containing nucleoplasm) is protoplasm. You should be aware of this when introducing the cytoplasm to learners so that this misconception can be avoided later on in their school career.
The cytoplasm (cytosol and organelles) and the nucleus together is referred to as protoplasm.
The cytoplasm includes all living parts of the cell within the cell membrane, but excluding the nucleus. The cytoplasm is made up of the cytosol and the cell organelles. The cytosol is a watery, jelly-like medium made of 70%-90% water, and is usually colourless.
The cytosol is a mixture of different substances dissolved in water. Do you remember what a mixture is from Matter and Materials? These substances within the cytosol include salts, various elements, such as sodium and potassium, and more complex molecules, such as proteins.
The cytosol is also where many chemical reactions take place. Next term, in Matter and Materials, we will learn more about chemical reactions.
The cell organelles making up the cytoplasm include mitochondria, chloroplasts and vacuoles. Vacuoles are organelles enclosed by a membrane and contain mostly water with other molecules in solution. The size and number of vacuoles within a cell varies greatly and depends on the type and function of the cell.

In this image of a plant cell, there are several vacuoles present, as is the case in many plant cells. The nucleus, with its dark nucleolus is also very clear. You can come back to this image a bit later to look at the nucleus again. If learners ask what the grey-white structure in the top left hand side is, this is a starch grain. Plants store starch grains within the cytoplasm. You can get your learners to provide labels for the vacuoles and cytoplasm in this image. Also visible is the cell wall of the plant cell - the cell membrane is the inner, more folded boundary, whereas the cell wall is the light grey, more rigid structure on the outside. Faintly visible are several mitochondria, for example the grey oval structures at the bottom left. Come back to this image once you have done these structures to add these labels in.

Plant and animal cells have a nucleus inside the cytoplasm. It controls all the processes and chemical reactions that take place inside the cell. The nucleus also contains the cell's genetic material which is organised into long DNA molecules.
The difference between eukaryotic and prokaryotic cells is that eukaryotic cells have a nucleus which contains the genetic material surrounded by a membrane. Prokaryotic DNA floats in the cytoplasm without a membrane.
The nucleus is structured as follows:
A double membrane called the nuclear membrane encloses the DNA. This nuclear membrane contains pores (holes) for substances to pass through.
There is a nucleolus inside the nucleus. This is often seen as a darker area within the nucleus.
The DNA contains information about inherited characteristics (hereditary), such as whether the person will have blue, brown or green eyes.
Have a look at the micrograph of a nucleus and the diagram of the nucleus.
Studying micrographs is a very important skill to develop for later in Life Sciences. Learners are often only exposed to schematic diagrams of cells which present an idealised view of the cell. They then find it very difficult to identify these structures within a micrograph of an actual cell. Encourage your learners to take note of how the diagram below was drawn and how it differs to the micrograph of the nucleus. Remind your learners that a micrograph is a photograph taken through a microscope, and in this case, a transmission electron microscope.

Researchers are starting to use DNA molecules to store data! In 2012 Harvard scientists were able to store 5.5 petabits (about 700 terabytes) of data on 1 gram of DNA! "DNA USB hard drives" are not available yet, however they might still be possible in your lifetime!
DNA is a very important part of all cells and therefore of all life. DNA contains information that encodes all our inherited traits or characteristics. This refers to characteristics which are passed down in families, such as your skin and eye colour, whether you have allergies and also the likelihood of contracting different types of illnesses.
Identical twins come from the same fertilised egg which splits in two. They have the same DNA. However, they are notexactly the same due to environmental factors that can influence how they develop. Non-identical twins developed from two different eggs and two different sperm.
Every organism has unique DNA. The difference in DNA that occurs between individuals is called variation. Even the slightest difference in DNA might cause significant variations within species and between species. Within species DNA differences or variations can lead to albino animals or the transference of similar illnesses, like sickle cell anemia.
Based on the work of many genetic researchers, we can now say that all humans share 99.9% identical DNA. The differences in the last 0.1% account for all the differences we see in humans.

Learn more about genes http://learn.genetics.utah.edu/content/begin/tour/
Do you remember that we spoke about food as the energy source for our bodies? Just as wood is burned to use the stored potential energy to make a fire to heat some water, the food that we eat needs to be broken down in order to release the energy so that our bodies can function. Mitochondria are responsible for doing this.
You can use this opportunity to revise what is meant by stored potential energy and the fact that food is seen as a fuel for our bodies.

Singular or Plural? mitochondrion is the singular and mitochondria is the plural form of the word.
Mitochondria are organelles enclosed by a double membrane. Cells that are very active would typically have more mitochondria than cells that are less active. Which type of cell, do you think, will have more mitochondria: a muscle cell or a bone cell?
A muscle cell will contain more mitochondria as muscle cells need a huge supply of energy for movement. You can point this out in the following image of mouse heart muscle tissue. Cardiac muscle tissue is very active and therefore needs a big energy supply, hence the frequency of mitochondria present in the tissue, as seen below.

Once food molecules enter the cells and pass into the mitochondria, they are used by the mitochondria in a process called cellular respiration. During respiration the mitochondrion can combine molecules from food with oxygen to release energy that the cell can use. Carbon dioxide, water and waste materials are by-products of this process.
Mitochondria have their ownmitochondrial DNA that is completely different to the DNA in the nucleus. What do you think we can we deduce from this fact?
With reference to the did you know fact in the margin about mitochondrial DNA, learners might ask what we can deduce from the fact that there is such a thing. One theory is that mitochondria originated from bacteria that invaded ancient eukaryotic cells and started living in a symbiotic relationship with the host, eventually losing its ability to live independently. This idea is still very controversial and not universally accepted. MtDNA seems to have an influence in gene expression and can be used to trace maternal lineage, since we inherit all of it from our mothers, not fathers.

Look at the micrograph of the mitochondrion in the image. What differences can you see between this mitochondrion and the diagram shown previously? In the diagram, it was very clear that the inner membrane folds, whereas in the micrograph it is not as easy to see this. This is because of the way that the cell was sectioned (cut) before it was viewed on the transmission electron microscope. In a diagram, we show an ideal representation of the organelle. But, when we view an actual organelle under a microscope, it may look quite different depending on how it was cut into a very thin section to view.
If you would like to find out how mitochondrial DNA (mtDNA) is responsible for 'old age', read this article by Dr Barry Starr from Stanford University http://genetics.thetech.org/ask/ask165
Now that you've studied the internal structure of a cell, let us summarise what we have learnt so far. Complete this table filling in the main function of each of the cell structures.
|
Cell Structure |
Function(s) |
|
Cell membrane |
|
|
Cytoplasm |
|
|
Nucleus |
|
|
Mitochondrion |
|
|
Vacuole |
|
Cell Structure |
Function(s) |
|
Cell membrane |
regulates / controls passage of substances in and out of cell |
|
Cytoplasm |
where many of the chemical reactions and processes in the cell takes place |
|
Nucleus |
contains DNA (hereditary material) of cell and controls the cell's activity |
|
Mitochondrion |
releases energy from food for the cell |
|
Vacuole |
stores substances, water, nutrients |
Now that we know what the main similarities are between all plant and animal cells, let's see how they are different.
Plant cells differ from animal cells
Why do plant and animal cells have differences? Plant and animal cells differ because they have to perform different functions.
Write differences that you observe in the table below the pictures of the cells.
|
Plant cells |
Animal cells |
 http://commons.wikimedia.org/wiki/File:Plagiomnium_affine_laminazellen.jpeg |
 |
|
Plant cells |
Animal cells |
 http://commons.wikimedia.org/wiki/File:Plagiomnium_affine_laminazellen.jpeg |
 |
|
|
All animal and plant cells are enclosed or surrounded by a cell membrane as we learned before. However, as you probably noticed in the previous activity, animal cells often have an irregular shape, whereas plant cells have a much more regular, rigid shape.
Plant cells have an additional layer surrounding the cell on the outside of the cell membrane. This is called the cell wall. This wall provides a protective framework for support and stability for the plant cell.
The cell wall is formed from various compounds, the main one being cellulose. Cellulose helps maintain the shape of the plant cell. This allows the plant to remain rigid and upright even if it grows to great heights.
Other organisms also have cell walls, like bacteria or fungi, but in these organisms their cell walls are not the same as plant cell walls. Only plant cells are made of cellulose.
You might remember learning about photosynthesis in previous grades. Can you still remember why photosynthesis is so important to all life on earth?
Use this opportunity to remind learners about photosynthesis and the fact that food chains always start with green plants, the producers. You can even write the word equation on the board: sunlight + carbon dioxide + water \(\rightarrow{}\) glucose + oxygen.
Did you notice the green organelles present in plant cells which were not there in the animal cells in the previous activity? These are chloroplasts. Chloroplasts are the only cell organelles that can produce food from the sun's energy. Only plants with chloroplasts are able to photosynthesise because they contain the very important green pigment, chlorophyll. Chlorophyll can absorb radiant energy from the sun and convert this to chemical energy that plants and animals can use. Animal cells lack chloroplasts and are not able to photosynthesise.

Learners do not have to know the internal structure of the chloroplast, but this micrograph shows this very clearly. So, you could point out the stacks of thylakoid discs, called a granum (darker, thick stripes) connected by lamellae (the thinner grey stripes in between the stacks). The chlorophyll pigments are embedded in the thylakoid disc membranes.
The sea slug,Elysia chlorotica, has evolved to take up the chloroplasts from the algae that it eats and incorporate them into its own cells where the chloroplasts function as if in a plant!
Article and video on the solar powered sea slug,Elysia chlorotica. http://www.newscientist.com/article/dn16124-solarpowered-sea-slug-harnesses-stolen-plant-genes.html
Does a plant have a skeleton? Turn to a friend and discuss what could possibly be used in a plant cell as a skeleton. Think for example of a blade of grass or a long stemmed rose.
Plants have cell walls to provide support and some learners might remember the vacuoles.
Vacuoles in plant cells are usually quite large organelles that can occupy as much as 90% of the cell's volume. The liquid in the vacuole, called cell sap, helps to support the plant. The full vacuoles push out against the cell wall and make the cells, and therefore the plant, rigid. We say the cells are turgid in this condition. The opposite to turgid is flaccid.

You can easily see when a plant's vacuoles are full and when they are not. When the vacuoles are full the plant's stem and leaves will be held upright and firm. However, if the leaves and stem are drooping, the vacuoles might have lost a lot of water because the soil is too dry and the cell was forced to use up this water to survive.
Vacuoles are only present in some animal cells and they are typically very small and have a short life-span.


Here are the labels for the animal and plant cell diagrams.

A typical animal cell.

A typical plant cell.
An example of the type of table that learners might produce is given below. Learners might present the information in a slightly different layout, which should be encouraged, if it is logical and legible. For example, they might not have the first column with the characteristic.
Table summarising the differences between plant and animal cells
|
Characteristic |
Animal cells |
Plant cells |
|
Shape |
Have an irregular shape |
Have a rigid, regular shape |
|
Cell wall |
Do not have a cell wall, only a cell membrane |
Have both a cell membrane and a cell wall. |
|
Vacuoles |
Have small vacuoles, which are often temporary or absent |
Have large vacuoles |
|
Chloroplasts |
Do not have chloroplasts |
Have chloroplasts to photosynthesise |
We use models all the time in science, whether they are actual built models out of materials, a mathematical model, or even models made using computer programmes. A model is a representation of an actual object or system to help us understand it.
In a 3D cell model, we will be making built models out of materials where we will use other objects to represent the actual parts of the cell.
INSTRUCTIONS :
This activity can be used as a project. Encourage learners to be creative when doing this task. They could make cell pizzas (with different toppings representing the organelles), cell jellies (with different fruits representing the organelles), or they may wish to use recycled items to represent the different functions of the organelles (such as batteries to represent mitochondria). The possibilities are endless.
Learners could create cell models out of playdough as an alternative option. Different colours can be created using different food colouring. The recipe for playdough is as follows:
Requirements for your cell model:
Although there is a general assessment rubric for models supplied in the Appendix of the Teacher's Guide, here is a more detailed rubric that you can use to assess your learners' models out of 40 marks. You can photocopy this rubric if you wish to provide it to your learners so that they know how they will be assessed.
TOTAL [40 marks]
Now that you have learnt all about different cells, are you ready to see them for yourself?
This section on microscopy is meant as an introduction as learners will need to be able to use microscopes later in this chapter, as well as if they carry on with Life Sciences in Gr. 10. Learning how to use an instrument is a very good skill. In Gr. 10 Life Sciences, learners will look at the different types of microscopes in more detail. Here, only light and electron microscopes are mentioned briefly.
Have you ever used a microscope before? Microscopes are instruments that are used to look at and study objects that are too small to be seen with the naked eye. Since the days of Hooke's observations, the development of microscopes has come a long way. Today we have incredibly powerful microscopes called electron microscopes which use electrons instead of light to observe very fine detail - even as small as a single column of atoms!

Learners would have been introduced to the atom in Gr. 8 Matter and Materials and perhaps before. The atom is the building block of all matter. The ability to visualise columns of atoms under a transmission electron microscope indicates how extremely powerful and high resolution these instruments are. A useful site for information about microscopy: http://micro.magnet.fsu.edu/primer/
Citizen science: Help out in cancer research from your own home! http://www.cellslider.net/
If microscopes are not available in your school, try building one with the learners' help! If Robert Hooke could do it without the wonderful technological marvels we have in our lives today, so can we! http://www.scienceinschool.org/2012/issue22/microscope or http://science.howstuffworks.com/light-microscope1.htm
Alternatively, organise to visit a school where microscopes are available and work alongside the learners at that school, or organise times when your school's learners can use the equipment when the laboratory is not being used.
Before we start working with microscopes, let's have a look at the different parts of a basic light microscope and the safety precautions we need to follow when using these pieces of equipment.

A microscope allows you to see detail in specimens that you cannot see with the naked eye. The image you see needs to be:
The next image explains the different parts of a light microscope and what they are used for.

When you use a microscope, make sure to follow these safety precautions:
To view cells under a microscope, we need to make and prepare something called a specimen on a slide.
A specimen is a small part or slice, or an example of an organism that we want to examine. When we view a specimen under a microscope it needs to let light pass through the specimen so we can see it. Therefore we need to prepare the specimen and cut extremely thin slices of less than 0.5 mm. Specimens are then placed on a glass slide.
We can prepare samples or specimens on a slide using these different techniques:
wet mount - good for observing living organisms and is especially used for aquatic samples
dry mount - good for observing hair, feathers, pollen grains or dust
smears are often made of blood or slime that is smeared over the slide and allowed to dry before observing them.
stains are added to wet or dry mounts by dropping colouring chemicals onto the specimens, like iodine solution, methylene blue or crystal violet. We use staining to improve the colour contrasts on the slide.
Video on making a wet mount slide.
We can use water, brine (salt water), glycerine or immersion oil for wet mounts.
This is an extension activity. It is optional and does not need to be done. However, if you do not have microscopes to work with at Gr. 9 level, this does provide an opportunity to get some experience with working with microscopes and troubleshooting problems, without actually using a real one.
INSTRUCTIONS:
Carefully study this image of onion cells that have been stained blue. Evaluate this image in terms of the focus, light and contrast visible in the photo.

Learners need to explain that the image is sharp and in focus, that there is enough light shone on the specimen and that the contrast is clearly well achieved to show the structures of the cells.
These same onion cells were viewed under a microscope which had not been adjusted properly and the following photos were taken. Identify what is wrong with the photograph compared to the one above.
|
Image |
What is wrong with the image? |
How could the image have been adjusted and corrected, using what part of the microscope? |
 |
||
 |
||
 |
|
Image |
What is wrong with the image? |
How could the image have been adjusted and corrected, using what part of the microscope? |
 |
The image is fuzzy. |
This image could have been focused using the fine and coarse adjustment screws. |
 |
The image is very dark. |
The brightness of the image could have been adjusted by changing the brightness of the lamp or moving the mirror to reflect more light onto the slide. The brightness can also be adjusted using the diaphragm and condenser apertures. |
 |
This image has poor contrast. |
The contrast of the image can also be adjusted by changing the intensity of the light and the diaphragm aperture. |
Learners might battle with the last image about contrast as this is quite tricky to understand, so you might have to explain the answer to them. The difference between brightness and darkness is that brightness refers to how light or dark an image is, whereas contrast refers to the difference in lighting between different areas of the specimen.
Before starting this activity, you could ask your learners why they think you are going to be making wet mounts, and not another type of mount, and what advantages using a liquid has. Have this as a class discussion and encourage your learners to take notes, either in a separate notebook or in the margin spaces within the workbook. We use liquid because:
There is a very specific way to prepare slides for viewing under a microscope. You will use this technique very often in Life Sciences to study specimens.
This activity will show learners how to prepare onion cells in a step-by-step manner, and will then challenge them to prepare their own cheek cells (using an ice cream stick or your own nail for collection) in order to study it under a microscope.
Very important: Make sure learners use clean, sterile sticks and that they do not re-use them and swop them.
If your class does not have access to a microscope, learners may still practice preparing a wet mount, and then examine the images at the end of the exercise.
MATERIALS:
Risk assessment: Some people are allergic to iodine and/or shellfish. If any learners are allergic to iodine or shellfish DO NOT use the iodine solution to stain your specimens. Methylene blue and crystal violet are harmful and can be irritants. Avoid contact with the skin.
INSTRUCTIONS:
You will need to work quite quickly as the onion cells will dry out!
Step 1: Prepare your microscope and slides as discussed in the safety methods above.
Step 2: Cut the onion into blocks of about 1 cm square with a sharp knife or scalpel.

Step 3: Use forceps to pull or peel a small piece of the very thin membrane-like epidermis lining off one of the inner layers of the onion.

Step 4: Place a drop of iodine solution onto the slide.

Step 5: Place the membrane directly in the drop on the slide.
Step 6: Gently lower a coverslip at an angle onto the onion cells. Hold the coverslip up with a dissection needle and gently lower the slip. This prevents air bubbles from getting trapped under the cover slip.

If you accidentally trapped an air bubble, gently press on the middle of the coverslip to get rid of any trapped air using the dissecting needle or drop some extra fluid right next to the edge of the coverslip.
Step 7: Wipe off excess fluid around the edge of the coverslip with tissue paper or filter paper.
Step 8: Make sure the lowest power objective lens (this is the shortest lens) is in line with the eyepiece. Switch on the lamp or use the mirror to reflect the light onto your stage. Place the prepared slide onto the stage and secure it with the stage clips.

Step 9: While on the low power, look from the side and lower the objective lens to just above the coverslip. Then look through the eyepiece and use the fine focus to focus your image. Viewing your specimen
Step 10: Magnify your cells by swapping the objective lens to a higher powered lens. Only use the fine focus adjustment to focus clearly.
Step 11: Make careful drawings of your observations in the space below and remember to label what you see. Add a heading including the specimen, the stain used and the magnification.
Learner-dependent answer
Did you see something like this?

Now that you have prepared slides of onion cell specimens, use a toothpick to gently scrape the inside of your cheek to collect cheek cells using the side of the toothpick or ice cream stick. Follow the same instructions as above to prepare the cheek cell specimen and to view it under the microscope. Draw and label the cheek cells that you viewed under the microscope in the space below.
Learner-dependent answer
Learners must gently scratch the inside of their cheeks to collect some cheek cells and then wipe the toothpick on the slide and cover with a drop of water. (Please ensure that learners scrape with the broad side of the toothpick, slowly and gently, so that they do not injure themselves!) Alternatively, learners can use old wooden ice cream sticks. The water droplet will most likely contain several cheek cells. It is going to be near impossible to see the cheek cells in water. You should use a stain to colour contrast the cells, namely methylene blue or iodine solution. These cells are MUCH smaller than onion cells and the learners may battle to find them - look for tiny blue/yellow 'flakes' that are not lying on top of each other and magnify a small group of 3-4 cells.
Did you see something like this?

Learners should be able to identify some of the following main differences and similarities between onion and cheek cells as:
This is an optional activity which learners can do outside of class if you have time.
The invention and improvement of microscopes has lead to incredible cellular discoveries (among others) in the last 400 years. Without microscopes, many of the microscopic organisms we know of today would never have been identified!
INSTRUCTIONS:
We looked at the basic differences between plant and animal cells. However, not all plant cells and not all animal cells are the same. Cells within an organism need to have different shapes and sizes because they fulfill different functions.
Look at the photo of the rose. Do you think the cells in the roots, stem, leaves, and petals of the rose all look the same?
The cells in the different parts of the rose all have to perform very specific functions and therefore have different sizes and shapes.


Your body contains a great number of specialised cells, meaning they have different functions. They have differences in their structures allowing them to have different functions. We say they have differentiated.
Do you remember we spoke about nerve cells and red blood cells briefly in the beginning of the chapter? Some of them are summarised in the following table.
|
Specialised cell |
Structure |
Function |
|
Epithelial cells - they are mostly flat |
 |
They cover the surface of the body for protection. |
|
Muscle cells - some are long and spindle shaped |
 |
Muscle cells can contract and relax allowing for movement within your body |
|
Nerve cells - the are very long and have branched ends |
 |
Nerve cells are specialised to carry messages that coordinate the functions of the body. |
|
Red blood cells - Round and biconcave shape |
 |
Red blood cells carry carry oxygen and carbon dioxide throughout the body. |
Stem cells are also harvested from the umbilical cord at birth and used for research. There are many ethical concerns regarding stem cell research. What do you think?
Stem cells are unspecialised cells which can divide and develop into many different types of specialised cells. Stem cells are quite amazing as they can divide and multiply while at the same time keeping their ability to develop into any other type of cell. Embryonic stem cells are the little ball of 50 -150 cells that forms 4-5 days after conception. Embryonic stem cells are very special as they can become absolutely any cell in the body, for example, blood cells, nerve cells, muscle cells or brain cells.
For this reason, scientists are using stem cells to conduct research. There are many benefits in doing this, but there are also many controversial and ethical issues surrounding stem cell research.
Are you curious about stem cell research? Find out more and discover the possibilities!
The syllabus does not require great detail on stem cells, but this is an exciting field of science that is growing rapidly. The potential uses of stem cell technology may capture the imagination and inspire learners. As a possible extension activity, get learners to do some reading about the topic of stem cell research. Then they can write down some of the main points and also write about their own opinions and feelings about the topic. The last step is to have a class discussion. Encourage each learner to give their opinion. You could do this as a class debate and break learners up into groups, or else just go around the class and ask each learner for their opinion and why.
Alternatively, you may wish to share the following exciting possibilities with learners. In the future stem cell therapy may be able to treat many different diseases, such as:
Alternatively, if resources cannot be found or if the terminology of stem cell research is too complex, this video on stem cells explains what the different stem cells are, what their normal role is in the normal body, and also explains some potential uses of stem cell technology .
Please ensure that learners understand the difference between microscopic and macroscopic and unicellular (single-celled) and multicellular (many-celled) organisms. Microscopic organisms are too small to be seen with the naked eye. Macroscopic organisms can be seen with the naked eye. Unicellular organisms consist of one cell, multicellular organisms are made up of many cells. Learners can easily become confused and think that all microscopic organisms are unicellular, but this is not the case! There are many multicellular organisms that are too small to be seen.
We have just looked at specialised cells within organisms. The organisms that we discussed, plants and animals, consist of many, many cells. Your body has millions of cells! Did you know that there are some organisms which consist of only a single cell? We have many different specialised cells to perform the different functions within our body whereas in a single-celled organism, all the functions it performs are done in this one cell. We can make a distinction between organisms that are made of one cell (unicellular) and those that are made of many cells (multicellular).
Microscopic and macroscopic describe whether an organism can be seen with the naked eye, while unicellular and multicellular refer to the number of cells an organism has.
We call one cell organisms that can only be seen with the help of a microscope microscopic organisms. There are many single-celled microscopic organisms. Have a look at the images.

Fresh water amoebae and
In contrast to microscopic single-celled organisms, macroscopic organisms are visible to the naked eye and consist of many cells. Macroscopic organisms can have a few cells working together or trillions of cells that form larger organisms.
In teaching this section, you may consider the example of the school as a 'living organism' in which:
Take a virtual tour of the human body http://medtropolis.com/virtual-body/
In microscopic single-celled organisms, the individual cell has to perform all the life processes for that microscopic organism.
So what about the cells in macroscopic organisms that consist of many cells? We have already learnt about specialised cells in macroscopic organisms, so we know that not all cells perform all the processes - they are specialised to perform a specific function.
Specialised cells that perform a specific function, group together to form a tissue. For example, muscle cells will group together to form muscle tissue, epithelial cells will group together to form the skin, and nerve cells will group together to form the brain and nerves.
Groups of tissues that work together form organs. Think of the stomach for example - it is made of many different specialised cells that form muscle tissue to make it contract and epithelial tissue (made from specialised epithelial cells) which lines the inside of the stomach and produces mucus.
Learn more about your body at this interactive website http://science.nationalgeographic.com/science/health-and-human-body/human-body/?source=G4101&kwid=ContentNetwork|929422345
When organs work together we say they form systems or organ systems. There are many different systems in your body where specific organs work closely together to make your body function. Have a look at the following diagram which shows how cells are organised into tissues in the stomach which form part of the digestive system in a human (the organism).

All the systems work together to form an organism. We will be looking at some of these systems later on in the term.
Learn more about the different systems in your body http://library.thinkquest.org/2935/Natures_Best/Nat_Best_High_Level/Title_Net_Page/Title_page_h.html
Have you noticed the VISIT boxes in the margins which contain links? You simply need to type this whole link into the address bar in your internet browser, either on your PC, tablet or mobile phone, and press enter, like this:

It will direct you to our website where you can watch the video or visit the webpage online. Be curious and discover more online on our website!
Concept map
Throughout this year, we are going to develop the skill of designing and makingconcept maps in Natural Sciences. The "Key concepts" listed above is a summary written out in full sentences. A concept map provides another way of representing information (ideas and concepts) in a more visual way. The benefits of a concept map are that it allows one to show the linkages between different concepts. Often a concept map has a "focus question" around which the other concepts radiate. In these books the focus question will be the main topic for the chapter. The relationships between different concepts are shown using arrows with linking phrases, such as "results in", "includes", "can be", "used to", "depends on", etc.
As this year progresses, learners will have to start filling in more parts of the concept maps themselves, and then hopefully draw their own ones by the end of the year. This teacher's guide contains the full version of each concept map. Encourage your learners to study the concept maps and make sense of them at the end of each chapter before doing the revision questions. Help your learners to understand and "read" the concept maps by constructing sentences from them. For example in this case you could read: "Cells in plants have some differences as only plants have chloroplasts for photosynthesis".
Learners need to learn how to learn! This is one skill which might help them later in their school career where they have a lot more information to learn and make sense of. Concept mapping is one tool to use to summarise information and understand how different concepts link together. Real understanding and knowledge comes from grappling with the subject matter, and not just memorising facts.
To learn more about concept maps and how they encourage learner understanding, visit this site: http://cmap.ihmc.us/publications/researchpapers/theorycmaps/theoryunderlyingconceptmaps.htm
"Knowledge is real knowledge only when it is acquired by the efforts of your intellect, not by memory." - Henry David Thoreau
This year in Natural Sciences, we are going to learn more about how to make our own concept maps.
In the summary, we first have the "Key concepts" for this chapter. This is a written summary and the information from this chapter is summarised using words. We can also create a concept map of this chapter which is a map of how all the concepts (ideas and topics) in this chapter fit together and are linked to each other. A concept map gives us a more visual way of summarising information.
Different people like to learn and study in different ways; some people like to make written summaries, whilst others like to draw their own concept maps when studying and learning. These are useful skills to have, especially for later in high school and after school!
Have a look at the concept map which shows what we have learned about the cell in this chapter and how these concepts link together. Can you see how the arrows show the direction in which you must "read" the concept map?
There are some empty spaces in the concept map that you need to fill in. For example, some of the common structures in cells have been left out. You need to look at the concepts linking from these bubbles to work out which structure goes where. For example, what structure in a cell encloses the cell contents? Write the answer in the correct space. On the left hand side of the concept map there are also empty spaces - can you see that this describes the hierarchy of how cells are organised into tissues, which are organised into organs, and so on? Fill in each level of organisation into the spaces.

Teachers version
Below is the complete concept map with the answers filled in. Make sure your learners understand what a concept map is and that they have filled in the correct concepts into the empty spaces.
Remember that concept maps are different to mind maps in that concept maps have a hierarchical structure and show how concepts link together using arrows and linking words. Whereas mindmaps generally contain a central topic and individual branches coming out which do not necessarily link together. Mindmaps can also be a useful way of summarising information and studying, however, we are using concept maps as they help to show linkages, which is very important in science. Help your learners to "read" the concept map by showing them that the arrows show the direction in which concepts progress and are linked to each other.

Learner-dependent answer. They should mention that cells are the smallest things that can live independently and are the most simple functional and structural unit that makes up all organisms.
Explain what selectively permeable means when referring to the cell membrane. [1 mark]
Selectively permeable means the membrane only allows certain substances to pass into and out of the cell.
Prokaryotic cells do not have a nucleus or membranes around the organelles, whereas eukaryotes have a nucleus and membrane bound organelles. May also refer to DNA being loose or enclosed in a membrane.
The nucleus controls all the processes inside the cell and the DNA carries the inherited characteristics of the organism.
mitochondrion
Learners should receive marks for following these drawing guidelines:
|
Smooth muscle tissue |
receives and sends messages and helps the body respond to stimuli |
|
Nerve cell |
carry oxygen around the body in mammals |
|
Red blood cells |
contracts and enables movement |
|
Macroscopic organisms consist of many different ________ that are made of individual ________ that work together in a very particular way. These are formed from ________that are in turned created when groups of ________ function together in a specific way.
Macroscopic organisms consist of many different organ systems that are made of individual organs that work together in a very particular way. These are formed from tissues that are in turned created when groups of specialised cells function together in a specific way.
Total [35 marks]
| Table of Contents |
Next
Chapter 2: Systems in the human body
|